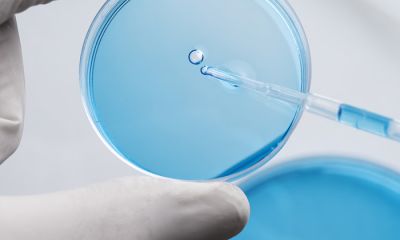

新闻中心
-
01/09
2026 -
01/05
2026公司主营产品涉及医药中间体、农药中间体、新材料、香精香料等,同时还为客户提供化学品的工艺开发,定制合成,委托生产等,我们坚持完善的质量管理体系,对产品和服务过程进行严密的、全方位的质量控制,确保为广大用户提供出可靠的产品和优质的服务。 -
12/29
2025 -
01/15
2020